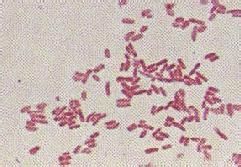
革蘭氏陰性桿菌感染

外膜阻止某些藥物和抗生素穿入細胞。這特徵說明為什麼革蘭氏陰性細菌一般較之革蘭氏陽性細菌更耐藥。 革蘭氏陰性細菌的外膜富含一種稱之為脂多糖的分子,如革蘭氏陰性菌進入血流脂多糖能激起疾病的暴發,包括發熱和血壓下降,因而脂多糖常被視為一種內毒素。 革蘭氏陰性細菌具有在同屬的菌株中,甚至在不同屬的菌株中極易發生遺傳物質(DNA)的交換,這就意味著如果一種革蘭氏陰性菌發生遺傳變化(突變)或者獲得了對某種抗生素耐藥的遺傳物質,這株細菌稍後可與另一株菌共有其DNA,第二株菌也就成為耐藥株。
相關詞條
-
革蘭氏陰性桿菌敗血症
多種原因引起的尿路黏膜的損傷,革蘭氏陰性桿菌侵入血流,均可引起敗血症。 和Thieme統計,在革蘭氏陰性桿菌敗血症中,由尿路感染引起者占55%。 據統計...
百科名片 臨床表現 治療 -
革蘭氏陰性球菌感染
革蘭氏染色法,能夠把細菌分為兩大類:採用這種染色方法,是先用龍膽紫來染病菌,所有細菌都染成了紫色,然後再塗以碘液,來加強染料與菌體的結合,再用95%的酒...
內容 -
革蘭陰性桿菌肺炎
革蘭氏陰性桿菌肺炎(呼吸內科)指克雷白桿菌、大腸桿菌、變形桿菌、流感嗜血桿菌或綠膿桿菌(銅綠假單胞菌)等革蘭氏陰性桿菌所致的肺炎,多數為繼發性肺炎。多見...
疾病概述 病理生理 症狀體徵 診斷檢查 治療方案 -
革蘭陰性桿菌
革蘭陽性菌、革蘭陰性菌是根據對細菌進行革蘭氏染色的結果來區分的,如果將細菌作革蘭氏染色,凡染後菌體呈紫色的,稱“革蘭氏陽性菌”, 菌體呈伊紅色,稱“革蘭...
特徵 實驗 革蘭氏染色反應 常見種類 治療方法 -
外科感染
外科感染一般是指需要手術治療的感染性疾病和發生在創傷或手術後的的感染,在外科領域中最常見,約占所有外科疾病的1/3~1/2。常分為特異性和非特異性感染。...
特點 分類 病因 化膿性致病菌 發病機制 -
腸病原的大腸埃希桿菌感染
腸病原性大腸埃希桿菌感染是由腸病原性大腸埃希桿菌(EPEC)引起的腸道傳染病。EPEC是早在20世紀40年代認識的一組致腹瀉性大腸埃希桿菌,50年代到6...
概述 疾病描述 症狀 治療 預防 -
軍團病桿菌感染
軍團病桿菌感染是軍團病桿菌引起的感染。特點是發熱﹑頭痛﹑肌痛﹑腹瀉及嘔吐﹐無死亡。
內容 配圖 所屬分類 -
革蘭氏陽性球菌感染
致病性葡萄球菌到處都有,健康成人前鼻孔帶此菌的約占30%,在皮膚上帶此菌的約20%.醫院病人和工作人員的帶菌率略高.在醫院和社區,耐抗生素菌株常見。
內容 配圖